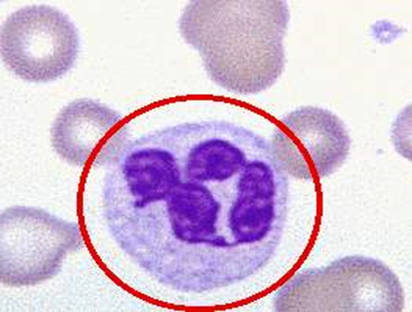
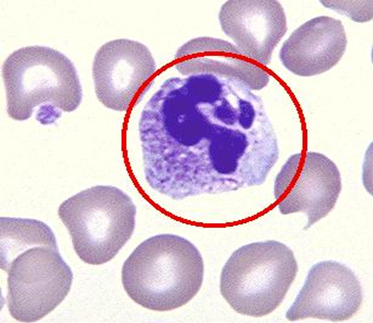

【学习目标】
掌握 有机溶剂的毒作用特点及特征性临床表现;特殊性预防措施。
苯、正己烷的毒理及慢性中毒的临床表现;
熟悉 有机溶剂对健康的影响;苯、正己烷的理化特性、接触机会、
了解 甲苯、二甲苯、二氯乙烷、二硫化碳的理化特性、接触机会、
毒理、临床表现、诊断、处理原则和预防措施。
第三章 生产性毒物与职业中毒 第五节 有机溶剂中毒
第三章 生产性毒物与职业中毒 第五节 有机溶剂中毒 授课视频
1. 概述
2. 苯中毒
3. 甲苯、二甲苯
4. 正己烷、二硫化碳
以下为参考资料:
第三章 生产性毒物与职业中毒 第五节 有机溶剂中毒课件
(一)概述
1.理化特性与毒作用特点 溶剂常态下为液体,通常是有机物,主要用作清洗剂、去油污剂、稀释和萃取剂;许多有机溶剂也用作原料以制备其它化学产品。工业溶剂约30,000余种,具有类似或不同理化特性和毒作用特点,现概述如下。
(1)挥发性、可溶性和易燃性:有机溶剂多易挥发,接触途径以吸入为主。脂溶性是有机溶剂的重要特性,进入体内易与神经组织亲和具有麻醉作用;又兼具水溶性,可经皮肤进入体内。有机溶剂大多具有可燃性,可用作燃料;有些则属于非可燃物,用作灭火剂如卤代烃类。
(2)化学结构:可以按照化学结构将有机溶剂分为若干类(族),同类者毒性相似,如氯代烃类多具有肝脏毒性,醚类都具有刺激性。基本化学结构为脂肪族、脂环族和芳香族;其功能基团包括卤素、醇类、酮类、乙二醇类、酯类、羧酸害、胺类和酰胺类基团。
(3)吸收与分布 挥发性有机溶剂经呼吸道吸入后经肺泡-毛细血管膜吸收,有40%~80%在肺内滞留;因有机溶剂多具脂溶性,多分布于富有脂肪的组织,包括神经系统和肝脏等;由于血-组织膜屏障富含脂肪,有机溶剂可分布于血液充足的骨骼和肌肉组织;肥胖者接触有机溶剂后,在体内蓄积量增多、排出慢;大多数有机溶剂可通过胎盘,经母乳排出,从而影响胎儿和乳儿健康。
(4)生物转化与排出:不同溶剂的代谢程度各异,代谢转化与有机溶剂人毒作用密切相关,如正在己烷的毒性与其主要代谢产生2,5-己二酮有关;有些溶剂,如三氯乙烯的代谢,与乙醇相似,可由于有限的醇和醛脱氢酶的竞争,而产生毒性的“协同作用”。有机溶剂主要以原形物经呼出气排出,少量以代谢物形式经尿排出。多数溶剂的生物半衰期较短。一般从数分钟到数天,故对大多数有机溶剂来说,生物蓄积不是影响毒作用的重要因素。
2.有机溶剂对健康影响
(1)皮肤:由有机溶剂所致的职业性皮炎,约占总例数的20%。几乎全部有机溶剂都能使皮肤脱脂或使脂质溶解而成为原发性皮肤刺激物。典型皮炎具有急性刺激性皮炎的特征,如红斑和水肿;亦可见慢性裂纹性湿疹。有些工业溶剂能引起过敏性接触性皮炎;少数甚至引起严重的剥脱性皮炎,如三氯乙烯。


三氯乙烯中毒(躯干皮肤红色斑丘疹) 三氯乙烯中毒(躯干皮肤红色斑丘疹)


三氯乙烯中毒(下肢皮肤红色斑丘疹) 三氯乙烯中毒(背部皮肤红色斑丘疹)


三氯乙烯中毒(发现早,治疗及时,比较轻微) 三氯乙烯中毒(严重病例)
图片来自朱博士QQ空间日志:http://user.qzone.qq.com/49014156/2
(2)中枢神经系统:几乎全部易挥发的脂溶性有机溶剂能引起中枢神经系统的抑制,多属于非特异性的抑制或全身麻醉。有机溶剂麻醉效能与脂溶性密切相关,麻醉效能还与化学结构有关。
(3)周围神经和脑神经:有机溶剂可引起周围神经损害,甚至有少数有机溶剂对周围神经系统呈特异毒性。如CS2、正己烷和甲基正-丁酮能使远端轴突受累,引起感觉运动神经对称性混合损害。三氯乙烯能引起三叉神经麻痹。
(4)呼吸系统:有机溶剂对呼吸道有一定刺激作用。高浓度的醇、酮和醛类还会使蛋白变性。长期接触刺激性较强的溶剂还可致慢性支气管炎。
(5)心脏:有机溶剂对心肝的主要影响是心肌对内源性肾上腺素的敏感性↑。曾有报道健康工人过量接触工业溶剂后可以发生心率不齐,如发生心室颤动,可致猝死。
(6)肝脏:在接触剂量大、接触时间长的情况下,任何有机溶剂均可导致肝细胞损害。卤素或硝基取代的有机溶剂对肝毒性尤其明显,芳香烃对肝毒性较弱。丙酮无肝脏毒性,但能加重乙醇对肝脏的作用。
作业工人短期内过量接触四氯化碳可产生急性肝损害;而长期较低浓度接触可出现慢性肝病(肝硬化)。
(7)肾脏:CCl4急性中毒时,常出现肾小管坏死性急性肾衰竭。多种溶剂或混合溶剂慢性接触可致肾小管性功能不全,出现蛋白尿、尿酶尿(溶菌酶、β葡萄糖苷酸酶、氨基葡萄糖苷酶的排出↑)。溶剂接触还可能与原发性肾小球性肾炎有关。
(8)血液系统:苯可以损害造血系统,导致WBC减少甚至全血细胞减少症,以至再障和白血病。某些乙二醇醚类能引起溶血性贫血或骨髓抑制性再生障碍性贫血。
(9)致癌:苯可引起急性或慢性白血病。
(10)生殖系统:大多数溶剂容易通过胎盘脂质屏障,还可进入睾丸。有些溶剂(如CS2)对女性生殖功能和胎儿的神经系统发育均有影响。

(二)苯及苯系物
1.苯(C6H6)
【理化特性】
苯(benzene)在常温下为带特殊芳香味的无色液体,分子量78,沸点80.1℃,极易挥发,蒸气比重为2.77。燃点为562.22℃,爆炸极限为1.4%~8%。易着火。微溶于水,易与乙醇、氯仿、乙醚、汽油、丙酮、二硫化碳等有机溶剂互溶。
【接触机会】
苯在工农业生产中被广泛使用:①作为有机化学合成中常用的原料,如制造苯乙烯、苯酚、药物、农药,合成橡胶、塑料、洗涤剂、染料,炸药等;②作为溶剂、萃取剂和稀释剂,用于生药的浸渍、提取、重结晶,以及油墨、树脂、人造革、粘胶和油漆等制造;③苯的制造,如焦炉气、煤焦油的分馏、石油的裂化重整与乙炔合成苯;④用作燃料,如工业汽油中苯的含量可高达10%以上。
【毒理】
(1)吸收、分布:苯在生产环境中以蒸气形式由呼吸道进入人体,经皮肤吸收量很少,虽经消化道吸收完全,但实际意义不大。苯进入体内后,主要分布在含类脂质较多的组织和器官中。一次大量吸入高浓度的苯,大脑、肾上腺与血液中的含量最高;中等量或少量长期吸入时,骨髓、脂肪和脑组织中含量较多。
(2)代谢:进入体内的苯,约有50%以原形由呼吸道排出,约10%以原形贮存于体内各组织,40%左右在肝脏代谢,近年研究认为骨髓也参与苯的代谢。肝微粒体上的细胞色素P450(CYP)至少有6种同工酶,其中2E1和2B2与苯代谢有关。在CYP的作用下苯被氧化成环氧化苯,环氧化苯与它的重排产物氧杂环庚三烯存在平衡,是苯代谢过程中产生的有毒中间体。通过非酶性重排,环氧化苯可生成苯酚,再经羟化形成氢醌(HQ)或邻苯二酚(CAT);环氧化苯在环氧化物水解酶(mEH)作用下也可生成为CAT。HQ与CAT进一步羟化则形成1,2,4-三羟基苯(1,2,4-BT)。在谷胱甘肽S-转移酶的催化下,环氧化苯与谷胱甘肽结合形成巯基尿酸(S-PMA),而通过羟化作用形成二氢二醇苯则进一步转化成反-反式粘糠酸(t,t-MA)。酚类化合物与葡萄糖醛酸或硫酸盐结合后随尿排出,故接触苯后,尿酚排出量增加。有时候中间产物可快速氧化生成反-反式粘糠酸,最后氧化成二氧化碳而被呼出。见图3-3。
尿中苯的代谢产物水平与空气中苯浓度存在相关性,因此,尿酚、HQ、CAT、t,t-MA及S-PAM均可作为苯的接触标志,其中S-PAM(苯巯基尿酸)在体内的本底值很低,且具有较好的特异性和半衰期,被认为是低浓度苯接触时的理想生物标志物,但吸烟可影响其测定值。

(3)毒作用机制:苯属于中等毒性。急性毒作用主要对中枢神经系统,以麻醉作用为主。高浓度的苯蒸气对眼睛、皮肤和呼吸道黏膜和皮肤有刺激作用,空气中苯浓度达2%时,人吸入后在5~10分钟内致死。
目前认为苯的血液毒性和遗传毒性主要是由其在体内的代谢过程中形成的代谢产物引起。苯的代谢产物被转运到骨髓或其他器官,可能表现为骨髓毒性和致白血病作用。迄今,苯的毒作用机制仍未完全阐明,目前认为主要涉及:①干扰细胞因子对骨髓造血干细胞的生长和分化的调节作用。骨髓基质是造血的微环境,在调节正常造血功能上起关键作用。苯代谢物以骨髓为靶部位,降低造血正调控因子白介素IL-1和IL-2的水平;活化骨髓成熟白细胞,产生高水平的造血负调控因子肿瘤坏死因子(TNF-α);②氢醌与纺锤体纤维蛋白共价结合,抑制细胞增殖;③DNA损伤,其机制有二,一是苯的活性代谢物与DNA共价结合形成加合物;二是代谢产物氧化产生的活性氧对DNA造成氧化性损伤。通过上述两种机制诱发突变或染色体的损伤,引起再生障碍性贫血或因骨髓增生不良,最终导致急性髓性白血病;④癌基因的激活。肿瘤的发生往往并非单一癌基因的激活,通常是两种或两种以上癌基因突变的协同作用。苯致急性髓性白血病可能与ras、c-fos、c-myc等癌基因的激活有关。
此外,慢性接触苯的健康危害程度还与个体的遗传易感性如毒物代谢酶基因多态、DNA修复基因多态等有关。
【临床表现】
(1)急性中毒:急性苯中毒是由于短时间吸入大量苯蒸气引起。主要表现为中枢神经系统的麻醉作用。轻者出现兴奋、欣快感、步态不稳,以及头晕、头痛、恶心、呕吐、轻度意识模糊等。重者神志模糊加重,由浅昏迷进入深昏迷状态或出现抽搐。严重者导致呼吸、心跳停止。实验室检查可发现尿酚和血苯增高。
(2)慢性中毒:长期接触低浓度苯可引起慢性中毒,其主要临床表现如下:
①神经系统:多数患者表现为头痛、头昏、失眠、记忆力减退等类神经征,有的伴有自主神经系统功能紊乱,如心动过速或过缓,皮肤划痕反应阳性,个别病例有肢端麻木和痛觉减退表现。
②造血系统:慢性苯中毒主要损害造血系统。有近5%的轻度中毒者无自觉症状,但血象检查发现异常。重度中毒者常因感染而发热,齿龈、鼻腔、黏膜与皮下常见出血,眼底检查可见视网膜出血。最早和最常见的血象异常表现是持续性白细胞计数减少,主要是中性粒细胞减少,白细胞分类中淋巴细胞相对值可增加到40%左右。血液涂片可见白细胞有较多的毒性颗粒、空泡、破碎细胞等。电镜检查可见血小板形态异常。中度中毒者可见红细胞计数偏低或减少;重度中毒者红细胞计数、血红蛋白、白细胞(主要是中性粒细胞)、血小板、网织细胞都明显减少,淋巴细胞百分比相对增高。严重中毒者骨骼造血系统明显受损,甚至出现再生障碍性贫血,骨髓增生异常综合征(MDS),少数可转化为白血病。

正常嗜中性粒细胞 中性粒细胞出现中毒颗粒
慢性苯中毒的骨髓象主要表现为:①不同程度的生成降低,前期细胞明显减少;轻者限于粒细胞系列,较重者涉及巨核细胞,重者三个系列都减低,骨髓有核细胞计数明显减少,呈再生障碍性贫血表现;②形态异常,粒细胞见到毒性颗粒、空泡、核质疏松、核浆发育不平衡,中性粒细胞分叶过多、破碎细胞较多等;红细胞有嗜碱性颗粒、嗜碱红细胞、核浆疏松、核浆发育不平衡等;巨核细胞减少或消失,成堆血小板稀少;③分叶中性粒细胞由正常的10%增加到20%~30%,结合外周血液中性粒细胞减少,表明骨的释放功能障碍。此外,约有15%的中毒患者,一次骨髓检查呈不同程度的局灶性增生活跃。
苯可引起各种类型的白血病,白血病以急性粒细胞白血病(急性髓细胞白血病)为多,其次为红白血病,急性淋巴细胞白血病(ALL)、单核细胞性白血病、慢性粒细胞白血病则很少见。国际癌症研究中心(IARC)已确认苯为人类致癌物。
③其他:经常接触苯,皮肤可脱脂,变干燥、脱屑以至皲裂,有的出现过敏性湿疹、脱脂性皮炎。苯还可损害生殖系统,苯接触女工月经血量增多、经期延长,自然流产胎儿畸形率增高;苯对免疫系统也有影响,接苯工人血IgG、IgA明显降低,而IgM增高。此外,职业性苯接触工人染色体畸变率可明显增高。
【诊断】 依据《职业性苯中毒的诊断》(GBZ68-2022)进行诊断。
【处理原则】
(1)急性中毒:应迅速将中毒患者移至空气新鲜处,立即脱去被苯污染的衣服,用肥皂水清洗被污染的皮肤,注意保暖。急性期应卧床休息。急救原则与内科相同,可用葡萄糖醛酸,忌用肾上腺素。病情恢复后,轻度中毒一般休息3~7天即可工作。重度中毒的休息时间,应按病情恢复程度而定。
(2)慢性中毒:无特效解毒药,治疗根据造血系统损害所致血液疾病对症处理。可用有助于造血功能恢复的药物,并给予对症治疗。再生障碍性贫血或白血病的治疗原则同内科。工人一经确定诊断,即应调离接触苯及其他有毒物质的工作。如需劳动能力鉴定,按GB/T16180处理。
【预防】由于苯是肯定的人类致癌物,发达国家在苯的应用方面均予以严格管理,以做到原始级预防。制造苯和苯用作化学合成原料均控制在大型企业,避免苯外流到中小企业,以限制作为溶剂和稀释剂的使用,如日本限制苯作为溶剂的用量为2%。近年,我国对苯的危害已高度重视,已逐步采取措施进行原始级预防,此外,还应加强:
(1)生产工艺改革和通风排毒:生产过程密闭化、自动化和程序化;安装有充分效果的局部抽风排毒设备,定期维修,使空气中苯的浓度保持低于国家卫生标准(6mg/m3,TWA;10mg/m3,PC-STEL)。

水旋式喷漆室
(2)以无毒或低毒的物质取代苯:如在油漆及制鞋工业中,以汽油、二乙醇缩甲醛、环己烷、甲苯、二甲苯等作为稀薄剂或粘胶剂;以乙醇等作为有机溶剂或萃取剂。
(3)卫生保健措施:对苯作业现场进行定期劳动卫生学调查,监测空气中苯的浓度。作业工人应加强个人防护,如戴防苯口罩或使用送风式面罩。进行周密的就业前和定期体检。女工怀孕期及哺乳期必须调离苯作业,以免对胎儿产生不良影响。
(4)职业禁忌证:血象指标低于或接近正常值下限者,各种血液病,严重的全身性皮肤病,月经过多或功能性子宫出血。
请看:央视网视频 > 远离毒素 > 远离毒素(六):苯 芳香杀手
http://tv.cntv.cn/video/C15773/c8b877fb886940a93046d59c07b59cc7
2.甲苯(C6H5CH3)、二甲苯[C6H4(CH3)2]
【理化特性】
均为无色无色透明,芳香气味、易挥发液体。甲苯沸点110.4°C,蒸气比重3.90。二甲苯有邻位、间位和对位异构体,其理化特性相近;沸点138.4~144.4°C,蒸气比重3.66。均不溶于水,可溶于乙醇、丙酮和氯仿等有机溶剂。
【接触机会】
用作化工生产的中间体,作为溶剂或稀释剂用于油漆、喷漆、橡胶、皮革等工业,也可作为汽车和航空汽油中的掺加成分。
【毒性】
甲苯、二甲苯可经呼吸道、皮肤和消化道吸收。吸收后主要分布在含脂丰富的组织,以脂肪组织、肾上腺最多,其次为骨髓、脑和肝脏。
甲苯80~90%氧化成苯甲酸,并与甘氨酸结合生成马尿酸,少量10%~20%为苯甲酸,可与葡萄糖醛酸结合,均易随尿排出。二甲苯60~80%在肝内氧化,主要产生为甲基苯甲酸、二甲基苯酚和羟基苯甲酸等,其中,甲基苯甲酸与甘氨酸结合生成甲基马尿酸,随尿排出。甲苯以原形经呼吸道呼出,一般占吸入量3.8%~24.8%,二甲苯经经呼吸道呼出的比例较甲苯少。
高浓度甲苯、二甲苯主要对中枢神经系统产生麻醉作用;对皮肤黏膜的刺激作用较苯为强,皮肤接触可引起皮肤红斑、干燥、脱脂及皲裂等,甚或出现结膜炎和角膜炎症状;纯甲苯、二甲
【临床表现】
(1)急性中毒 短时间吸入高浓度甲苯和二甲苯可出现中枢神经系统功能障碍和皮肤粘膜刺激症状。轻者表现头痛、头晕、步态蹒跚、兴奋,轻度呼吸道和眼结膜的刺激症状。严重者出现恶心、呕吐、意识模糊、躁动、抽搐,甚至昏迷,呼吸道和眼结膜出现明显刺激症状。
(2)慢性中毒 长期接触中低浓度甲苯和二甲苯可出现不同程度头晕、头痛、乏力、眨眼障碍和记忆力减退等症状。末梢血象可出轻度、暂时性改变,脱离接触后可恢复正常。皮肤接触可致慢性皮炎、皮肤皲裂等。
【诊断】 依据职业性急性甲苯中毒的诊断标准(GBZ 16-2014)
(1)诊断原则:根据短期内吸入较高浓度甲苯蒸气或皮肤黏膜接触大量甲苯液体的职业史、出现以中枢神经系统损害为主的临床表现,参考现场职业卫生学资料,综合分析,并排除其他病因所致类似疾病后,方可诊断。
(2)接触反应:短期内接触甲苯后出现头晕、头痛、恶心、呕吐、胸闷、心悸、颜面潮红、结膜充血等,脱离接触后72h内明显减轻或消失。
(3)诊断分级
①轻度中毒:短期内接触大量甲苯后出现明显头晕、头痛、恶心、呕吐、胸闷、心悸、乏力、步态不稳,并具有下列表现之一者:
a)轻度意识障碍(见GBZ76);
b)哭笑无常等精神症状。
②中度中毒 在轻度中毒基础上,具有下列情况之一者:
a)中度意识障碍(见GBZ76);
b)妄想、精神运动性兴奋、幻听、幻视等精神症状。
③重度中毒:在中度中毒基础上,具有下列情况之一者:
a)重度意识障碍(见GBZ76);
b)猝死(见GBZ78)。
【处理原则】
(1)急性中毒:应迅速将中毒患者移至空气新鲜处,急救原则同内科处理原则。可给予葡萄糖醛酸和硫代硫酸钠以促进甲苯的排泄;病情恢复后,一般休息3~7天即可工作,较重者可适当延长休息时间,病痊后可恢复原工作。
(2)慢性中毒:主要是对症治疗。轻度中毒患者治愈后可恢复原工作;重试中毒昌都应调离原工作岗位,并根据病情恢复情况安排休息或工作。
【预防】
(1)降低空气中的浓度:通过工艺改革和密闭通风措施,将空气中甲苯、二甲苯浓度控制在国家卫生标准以下(二者均为50mg/m3,TWA;100mg/m3,PC-STEL)。
(2)加强对作业工人的健康检查:做好就业前和2年一次的定期健康检查工作。
(3)卫生保健措施:同苯
职业禁忌证:神经系统器质性疾病,明显的神经衰弱综合征,肝脏疾病。
(三)二氯乙烷(dichloroethane)
【理化特性】
二氯乙烷(C2H4Cl2)分子量98.97,室温下为无色液体,易挥发,有氯仿样气味。有两种同分异构体:1,2-二氯乙烷(对称异构体)和1,1-二氯乙烷(不对称异构体)。1,2-二氯乙烷的沸点83.5℃,在空气中的爆炸极限为6.2~15.9%,1,1-二氯乙烷的沸点57.3℃;蒸汽比重均为3.40。难溶于水,可溶于乙醇和乙醚等有机溶剂,是脂肪、橡胶、树脂等的良好溶剂。遇热、明火、氧化剂易燃、易爆,加热分解可产生光气和氯化氢。
【接触机会】
二氯乙烷在工农业上的应用历史悠久,1848年曾用作麻醉剂,1927年发现有杀虫作用,又用作谷物、纺织品等的熏蒸剂。目前主要用于制造氯乙烯单体、乙二胺等化学合成的原料、工业溶剂和粘合剂,还用作纺织、石油、电子工业的脱脂剂,金属部件的清洁剂,咖啡因等的萃取剂等。
【毒理】
二氯乙烷两种异构体常以不同比例共存,1,2-二氯乙烷属高毒类;1,1-二氯乙烷属微毒类。1,2-二氯乙烷易经呼吸道、消化道和皮肤吸收,职业接触主要经呼吸道吸入,进入机体后主要分布在肝脏、肾脏、心脏、脊髓、延髓、小脑等靶器官。
主要代谢途径:①通过细胞色素P-450介导的微粒体氧化,产物为2-氯乙醇和2-氯乙醛,随后与谷胱甘肽结合;②直接与谷胱甘肽结合形成S-(2-氯乙基)-谷胱甘肽,随后被转化成谷胱甘肽环硫化离子(glutathione episulfonium ion),可与蛋白质、DNA或RNA形成加合物。1,2-二氯乙烷在血液中的生物半减期为88分钟。动物实验表明,机体吸收的1,2-二氯乙烷,约22~57%以原形和二氧化碳形式呼出,51~73%经尿排出,0.6~1.3%潴留于体内。尿中主要代谢物为硫二乙酸和硫二乙酸亚砜(thiodiaceticacid sulfoxide)。1,1-二氯乙烷在体内的生物转运和转化目前尚不清楚。
二氯乙烷毒作用的主要靶器官为神经系统、肝脏和肾脏,对中枢神经系统的麻醉和抑制作用突出;可引起中毒性脑病,甚至导致死亡,初步研究结果显示中毒性脑病的病理基础是脑水肿,与兴奋性氨基酸的神经毒性作用以及脑细胞能量代谢障碍有关。1,2-二氯乙烷还具有心脏、免疫和遗传毒性。1,1-二氯乙烷的毒性仅是对称体的1/10,吸入一定浓度可引起肾损害,反复吸入也可致肝损害。1,1-二氯乙烷的毒作用机制尚不清楚。
【临床表现】
二氯乙烷中毒事故的发生多数由于吸入1,2-二氯乙烷所致,单独由1,1-二氯乙烷引起的中毒还未见报道。
1.急性中毒 急性二氯乙烷中毒是由于短期接触较高浓度的二氯乙烷后引起的以中枢神经系统损害为主的全身性疾病。潜伏期短,一般为数分钟至数十分钟。患者出现头晕、头痛、烦躁不安、乏力、步态蹒跚、颜面潮红、意识模糊,有时伴有恶心、呕吐、腹痛、腹泻等胃肠症状。重者可突发脑水肿,出现剧烈头痛、频繁呕吐、谵妄、抽搐、浅反射消失、病理反射出现阳性体征、昏迷,少数患者肌张力明显下降。临床死因多为脑水肿并发脑疝。临床上患者病情会出现反复,患者昏迷后清醒,可再度出现昏迷、抽搐甚至死亡应引起重视。患者数天后会出现肝、肾损伤。
2.亚急性中毒 是我国近年来主要的发病形式。见于较长时间、接触较高浓度二氯乙烷的中毒患者。临床特点与急性中毒有所不同:潜伏期较长,多为数天甚至十余天。临床表现为中毒性脑病,肝、肾损害少见;多呈散发性;起病隐匿,病情可突然恶化。
3.慢性中毒 长期吸入低浓度的二氯乙烷可出现乏力、头晕、失眠等神经衰弱综合征表现,也有恶心、腹泻、呼吸道刺激及肝、肾损害表现。少数病人有肌肉和眼球震颤症状。皮肤接触可引起干燥、脱屑和皮炎。
4.致癌、致畸、致突变作用
1998年国际化学品安全规划署(IPCS)公布了1,2-二氯乙烷对人和/或环境的潜在效应评价结果,认为1,2-二氯乙烷摄入可增加大鼠及小鼠血管肉瘤、胃癌、乳腺癌、肝癌、肺癌以及子宫肌瘤的发生率,小鼠皮肤重复接触或腹腔注射可增加肺癌的发生率;人群调查资料结果不肯定。致畸作用不明显。
【诊断】 诊断标准为《职业性急性1,2-二氯乙烷中毒诊断标准》(GBZ 39-2002)。
1.诊断原则:根据短期接触较高浓度二氯乙烷的职业史和以中枢神经系统损害为主的临床表现,结合现场劳动卫生学调查,综合分析,排除其他病因所引起的类似疾病,方可诊断。
2.接触反应 短期接触较高浓度二氯乙烷后,出现头晕、头痛、乏力等CNS症状。可伴恶心、呕吐或眼及上呼吸道刺激症状,脱离接触后短时间消失者。
3.诊断及分级标准
(1)轻度中毒:出现下列一项表现者:a)步态蹒跚;b)轻度意识障碍,如意识模糊、嗜睡状态、朦胧状态;c)轻度中毒性肝病;d)轻度中毒性肾病。
(2)重度中毒:出现下列一项表现者:a)中度或重度意识障碍;b)癫痫大发作样抽搐;c)脑局灶受损表现,如小脑性共济失调等;d)中度或重度中毒性肝病。
治疗成功的关键在于早期明确诊断,针对脑缺氧和脑水肿采取积极措施。
【处理原则】
1.现场处理 应迅速将中毒者脱离现场,移至新鲜空气处,更换被污染的衣物,冲洗污染皮肤,注意保暖,并严密观察,防止病情反复。
2.接触反应者应密切观察,并给予对症处理。
3.急性中毒以防治中毒性脑病为重点,积极治疗脑水肿,降低颅内压。目前尚无特效解毒剂,治疗和观察时间一般不应少于2周。恢复期忌饮酒和剧烈运动。重度中毒者恢复后应调离二氯乙烷作业。
4.慢性中毒 主要是补充多种维生素、葡萄糖醛酸、三磷酸腺苷、肌苷等药物以及适当的对症治疗。
【预防措施】
1.降低空气中1,2-二氯乙烷的浓度:加强密闭、通风,严格控制作业场所空气中浓度低于国家卫生标准(7mg/m3,PC-TWA;15mg/m3,PC-STEL),加强生产环境中毒物浓度日常监测。
2.加强作业人员的健康监护和健康教育:重视接触工人的健康监护并对作业工人进行职业健康促进教育,提高作业人员的防护意识。
职业禁忌症:神经系统器质性疾病,精神病,肝、肾器质性疾病,全身性皮肤疾病。
(四)正己烷(n-hexane)
【理化特性】
正己烷(n-hexane)是己烷(C6H14)主要的异构体之一,化学式CH3(CH2)4CH3,分子量86.18。微有异臭的液体。易挥发,蒸气比重为2.97。沸点68.74ºC,自燃点为225ºC。几乎不溶于水,易溶于氯仿、乙醚、乙醇。
【接触机会】
正己烷用作提取植物油与合成橡胶的溶剂,试剂和低温温度计的溶液,还用于制造胶水、清漆、粘合剂和其它产品。尤其在鞋用黏合剂中使用较多。
请看视频:深圳市宝安区疾病预防控制中心——清洗与粘胶工职业中毒的预防
请看视频:2010年2月21日焦点访谈——无尘车间的怪病(部分)
【毒理】
1.吸收 正己烷在生产环境中主要以蒸气形式经呼吸道吸收,可经皮肤吸收;也可以胃肠道吸收。
2.分布 正己烷与器官的脂肪含量有关,主要分布于血液、神经系统、肾脏、脾脏等。
3.代谢 主要在肝脏代谢,在微粒体混合功能氧化酶系参与下,通过(ω-1)-氧化,生成一系列代谢产物,如2-己醇,2己酮,2,5-己二醇,5-羟基-2-己酮,2,5-己二酮等,其中尤以2,5-己二酮重要。生物转化过程(图3-4)。上述代谢产物主要与葡萄糖醛酸结合,结合产物随尿排出。

正己烷在体内代谢受其他化学物的影响较大,如甲苯可减慢代谢;丙酮、甲基乙基酮、异丙醇可加速其代谢。
4.毒性 正己烷急性毒性属低毒类,但毒性比辛己烷、庚烷大。主要为麻醉作用和对皮肤、黏膜的刺激作用。高浓度可引起可逆的中枢神经功能抑制。
长期接触正己烷,可致多发性周围神经病变。正己烷对皮肤的长期刺激作用可致皮肤红斑、水肿、水疱等。
正己烷生殖系统毒性作用近年来引起关注,其代谢产物2,5-己二酮可致实验动物睾丸、附睾重量减轻,曲细精管上皮细胞空泡化,精子形成障碍等。
5.毒作用机制 还不清楚,它可影响全身多个系统,且主要与其代谢产物2,5-己二酮有关。目前认为正己烷诱发多性性周围神经病变是由于其代谢产生2,5-己二酮与神经微丝中蛋白中的赖氨酸共价,生成2,5-二甲基吡咯加合物,导致神经微丝积聚,引起轴突运输障碍和神经纤维变性。也有人认为2,5-己二酮与神经纤维内糖酵解酶结合致细胞能量代谢障碍和神经变性。2,5-己二酮进入眼房水和视网膜,并透过血-眼房水/视网膜屏障,引起光感细胞的丢失。
【临床表现】
1.急性中毒:急性吸入高浓度的正己烷可出现头晕、头痛、胸闷、眼和上呼吸道粘膜刺激及麻醉症状,甚至意识障碍。经口摄入可引起恶心、呕吐、支气管和胃肠道刺激症状,也可出现中枢神经抑制及急性呼吸道损害等。
2.慢性中毒 长期职业性接触,主要累及以下系统:
(1)神经系统:以多发性周围神经病变最为重要,其特点为起病隐匿且进展缓慢。四肢远端有程度和范围不等的触痛觉减退,多在肘及膝关节以下,一般呈手套、袜子型分布;腱反射减退或消失;感觉和运动神经传导速度减慢。较重者可累及运动神经,常伴四肢无力,肌肉痉挛样疼痛,肌力↓,部分有肌萎缩,以四肢远端较为明显。严重者视觉和记忆功能缺损。


正己烷中毒打工妹唐文艳 正己烷中毒丧失行动能力


正己烷中毒 正己烷中毒
(2)心血管系统:表现为心律不齐,特别是心室颤动,心肌细胞受损。
(3)生殖系统:表现为男性性功能障碍,如性欲下降等,重者出现阳痿;精液检查:精子数目减少,活动能力下降。
(4)其他:血清免疫球蛋白IgG、IgM、IgA水平受到抑制。皮肤黏膜可因长期接触正己烷央出现非特异性慢性损害。
【诊断】 诊断标准:职业性慢性正己烷中毒诊断标准GBZ84-2002。
1.诊断原则:长期接触正己烷的职业史,出现以多发性周围神经损害为主的临床表现,结合实验室检查及作业场所卫生学调查,综合分析,排除其他原因所致类似疾病后,方可诊断。
2.观察对象长期接触正己烷后无周围神经损害体征,但具有以下一项者:a)肢体远端麻木、疼痛,下肢沉重感,可伴有手足发凉、多汗。食欲减退、体重减轻、头昏、头痛等;b)神经-肌电图显示可疑的神经源性损害。
3.诊断及分级标准
(1)轻度中毒 上述症状加重,并具有以下一项者:
a)肢体远端出现对称性分布的痛觉、触觉或音叉振动觉障碍,同时伴有跟腱反射减弱;
b)神经-肌电图显示有肯定的神经源性损害。
(2)中度中毒 在轻度中毒的基础上,具有以下一项者:
a)跟腱反射消失;b)下肢肌力4度;
c)神经-肌电图显示神经源性损害,并有较多的自发性失神经电位。
(3)重度中毒 在中度中毒的基础上,具有以下一项者:
a)下肢肌力3度或以下;b)四肢远端肌肉明显萎缩,并影响运动功能。
【处理原则】 正己烷中毒无特殊解毒剂。
1.急性中毒:立即脱离接触,移至空气新鲜处,用肥皂水清洗皮肤污染物,并作对症处理。如中西医综合疗法,辅以针灸、理疗和四肢运动功能锻炼等。
2.慢性中毒:有多发性周围神经病变,应尽早脱离接触,予以对症和支持治疗。
轻度中毒者痊愈后可生返原工作岗位,中度及重度患者治愈后不宜再从事接触正己烷以及其他可引起周围神经损害的工作。
【预防】
1.控制触浓度 通过工艺改革减少正己烷的直接接触与使用量,加强局部密闭通风,降低空气中正己烷浓度100mg/m3(TWA),180mg/m3(PC-STEL)。
2.加强个人防护与健康监护 应带防护口罩、穿防护服,严禁用正己烷洗手。建立上岗前和在岗期间体检制度,对患有神经系统和心血管系统疾病的作业工人,应密切观察。定期体检,应特别注意周围神经系统的检查。
3.完善管理 提高防患意识,完善职业卫生管理制度,加强健康教育,加强职业卫生管理,健全法律法规。
(夏昭林)
(五)二硫化碳(carbon disulfide,CS2)
【理化特性】
二硫化碳(carbon disulfide,CS2),分子量76.14,常温下为液体。纯品无色,具芳香气味,工业品为浅黄色,有烂萝卜气味。沸点46.5℃,蒸汽比重2.62,易燃,易挥发。与空气形成易爆混合物,爆炸下限及上限为1.0%和50.0%。几乎不溶于水,可与苯、乙醇、醚及其他有机溶剂混溶,腐蚀性强。
【接触机会】
CS2是重要的化工原料,主要用于粘胶纤维和玻璃纸生产。在此过程中,CS2与碱性纤维素纤维素磺原酸酯和三硫碳酸钠。经纺丝槽生成粘胶丝,再通过硫酸凝固为人造粘胶纤维,释放出多余的CS2;同时,三硫碳酸钠与硫酸作用时,除CS2外还可产生硫化氢。另外,在玻璃纸和四氯化碳制造、橡胶硫化、谷物熏蒸、石油精制、清漆、石蜡溶解以及用有机溶剂提取油脂时也可接触到CS2。


温州一内装20吨CS2槽罐车泄漏 辽宁丹东二CS2泄漏
【毒理】
CS2主要经呼吸道进入体内,也可由消化道和皮肤摄入。吸入的CS2有40%被吸收。被吸收的CS2有10~30%以原型从呼气中排出;70~90%在体内转化,以代谢产物形式从尿中排出。其中,2-硫代噻唑烷-4-羧酸(2-thiothiazolidine-4-carboxylie acid, TTCA)是CS2经P-450活化与还原型谷胱甘肽结合所形成的特异性代谢产物,TTCA与接触CS2浓度有良好的相关关系,可作为CS2的生物学监测指标,反映CS2的近期暴露情况。
CS2可透过胎盘屏障。在CS2接触女工胎儿脐带血中和乳母乳汁中可检测出CS2。
CS2是以神经系统损伤为主的全身性毒物,急性毒性以神经系统抑制为主,慢性中毒主要表现为周围神经病。尚未发现致癌性和诱变性。
CS2的毒作用机制尚不清楚。CS2可选择性地损害中枢神经及周围神经,特别是脑干和小脑,引发急性血管痉挛。目前认为,CS2在体内生物转化的氧化脱硫反应中生成的氧硫化碳(COS)可进一步释出高活性的硫原子,其对靶细胞具有氧化应激效应。因此CS2在体内生成的自由基是导致组织损伤的启动机制。CS2可抑制体内许多重要的代谢酶的活性进而产生多种毒作用。如:可通过与铜、锌、钴等离子络合反应而抑制多巴胺-β-羟化酶活性,体内多巴胺增加,去甲肾上腺素减少,出现儿茶酚胺代谢紊乱,进而导致锥体外系的损害。
CS2能直接与轴索中的骨架蛋白作用,导致神经丝蛋白分子内和分子间的交叉联接(cross-linking),从而破坏轴索的骨架结构,还可以破坏细胞能量代谢,导致轴浆运输障碍。CS2可抑制单胺氧化酶活性,引起脑中5-羟色胺堆积,这可能是CS2引起精神行为障碍的可能机制。CS2亦可干扰维生素B6的代谢,进而影响维生素B6依赖酶的活性,这可能与多发性神经病、自主神经功能失调及神经轴索脱髓鞘改变有关联。CS2还可能通过损伤垂体促性腺激素细胞以及性腺(睾丸和卵巢)结构功能等而导致生殖毒性。可能通过影响体内脂质代谢平衡状态,尤其是干扰脂质的清除等而促进全身小动脉硬化的形成。CS2慢性中毒中最常见的改变是终端感觉运动神经病变,研究认为CS2在体内与蛋白质的氨基发生反应生成二硫代氨基甲酸酯等物质引起蛋白质的分子内或分子间的共价交联有关。
【临床表现】
1.急性中毒:一般是突发性生产事故所致。急性中毒时主要造成中枢神经系统损伤,精神失常症状是CS2急性中毒的特征性表现。若短时间吸入高浓度(3000~50000mg/m3)CS2,可出现明显的神经精神症状和体征,如明显的情绪异常改变,出现谵妄、躁狂、易激怒、幻觉妄想、自杀倾向,以及记忆障碍、严重失眠、食欲丧失、胃肠功能紊乱、全身无力等,可进展为强直痉挛样抽搐、昏迷。
2.慢性中毒
(1)神经系统:包括中枢和外周神经损伤,毒作用表现多样,轻者表现为易疲劳、嗜睡、乏力、记忆力减退,严重者出现神经精神障碍;外周神经病变以感觉运动功能障碍为主,常由远及近、由外至内进行性发展,表现为感觉缺失、肌张力减退、行走困难、肌肉萎缩等。中枢神经病变常同时存在。CT或MRI检查可显示有局部和弥漫性脑萎缩表现,肌电图检测可见外周神经病变,神经传导速度减慢。神经行为测试表明:长期接触CS2可致警觉力、智力活动、情绪控制能力、运动速度及运动功能方面的障碍。
(2)心血管系统:研究显示,CS2接触者中冠心病死亡率增高;与中毒性心肌炎、心肌梗死间可能存在联系等。此外,尚有出现视网膜动脉瘤、全身小动脉硬化等临床报告。
3)视觉系统:CS2对视觉的影响早在十九世纪就有报道。可见眼底形态学改变,灶性出血、渗出性改变、视神经萎缩、球后视神经炎、微血管动脉瘤和血管硬化。同时,色觉、暗适应、瞳孔对光反射、视敏度,以及眼睑、眼球能动性等均有改变。眼部病变可以作为慢性CS2毒作用的早期检测指标。
4)生殖系统:女性月经周期异常,出现经期延长、周期紊乱、排卵功能障碍、流产或先兆流产等。
【诊断】 诊断标准是《职业性慢性二硫化碳中毒诊断标准》(GBZ 4-2002)。
1.诊断原则
(1)急性CS2中毒 主要根据在短期内接触较高浓度CS2,以及典型的神经精神症状和体征。
(2)慢性二硫化碳中毒 应根据长期密切接触二硫化碳的职业史,具有多发性周围神经病的临床、神经-肌电图改变或中毒性脑病的临床表现,经综合分析,排出其他病因引起的类似疾病,方可诊断。
2.观察对象 具有以下任何一项者:
a)头痛、头昏、乏力、睡眠障碍、记忆力减退或下肢无力、四肢发麻等症状;
b)眼底出现视网膜微动脉瘤;
c)神经-肌电图显示有可疑的神经源性损害而无周围神经损害的典型症状及体征。
3.诊断及分级标准
(1)轻度中毒:具有以下任一项者:
a)四肢对称性手套、袜套样分布的痛觉、触觉或音叉振动觉障碍有跟腱反射↓;
b)上述体征轻微或不明显,但神经-肌电图显示有神经源性损害
(3)重度中毒 具有以下任何一项者:
a)四肢远端感觉障碍、跟腱反射消失,伴四肢肌力明显下降或四肢远端肌肉萎缩者;肌电图显示神经源性损害,伴神经传导速度明显减慢或诱发电位明显降低;
b)中毒性脑病;c)中毒性精神病。
【处理原则】
对急性中毒患者应立即脱离接触,积极防治脑水肿,控制精神症状。确诊慢性中毒者应调离接触CS2的工作。若及时发现和处理,预后良好;一旦出现多发性神经炎或中枢性神经受损征象,则病程迁延,恢复较慢。观察对象一般可不调离,但应半年复查一次神经-肌电图检查;慢性轻度中毒患者应调离,经治疗恢复后,可从事其他工作,并定期复查;慢性重度中毒经治疗后,应调离CS2和其他对神经系统有害的作业。
对CS2中毒尚无特效解毒药,主要是对症处理,可用B族维生素、能量合剂,并辅以体疗、理疗及其他对症治疗。重度中毒同时加强支持疗法。
【预防措施】
1.严格执行我国车间空气中CS2职业卫生标准(5mg/m3,PC-TWA;10mg/m3, PC-STEL)。粘胶纤维生产过程应加强生产设备的密闭,并采用吸风装置,加强环境监测。
2.特别注意管道、设备的检修,防止跑、冒、滴、漏发生。
3.做好就业前体检和定期健康检查,包括神经系统、心血管系统和生殖系统的检查,完善健康档案,切实搞好职业健康促进,加强岗位安全教育,提高工人自我保护意识。
(尹立红)

